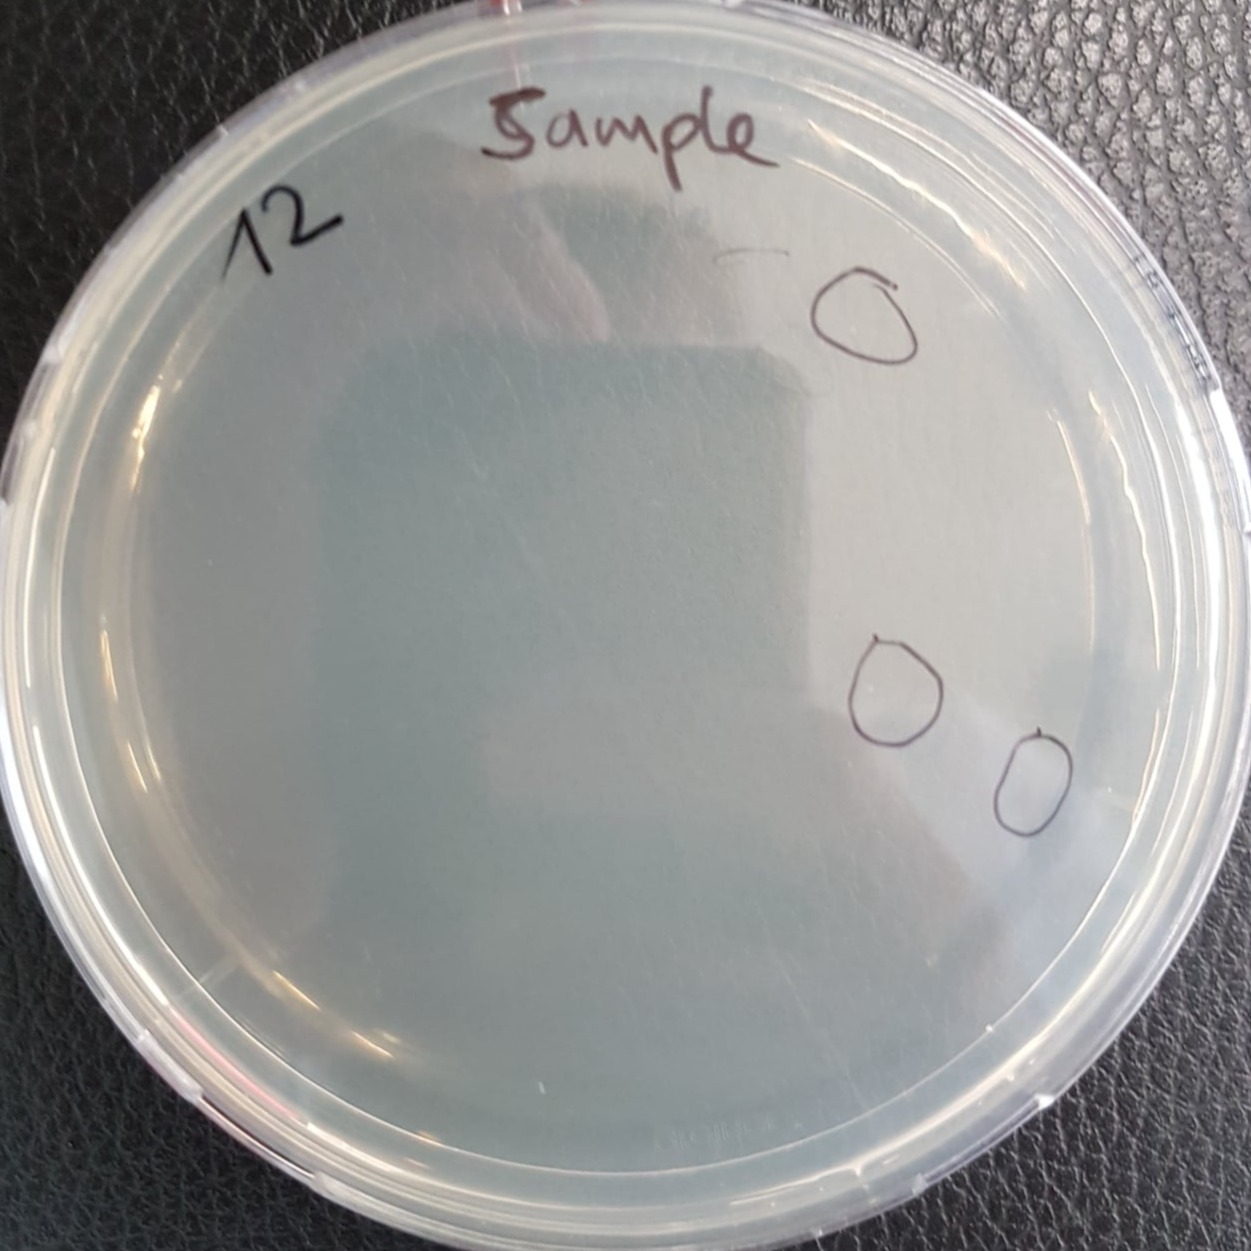
Mobirise Website Builder

Mikrobiologisches Testen
Mikroben anzüchten
Ich kann dir mittels verschiedenster Agarplatten Mikroben nachweisen, die sich in deiner Probe jeglicher Art verstecken. Durch Blutagar und weiterer Differenzierungen, sowie die Ausbrütung unter verscchiedener Temperaturen, lässt sich dann auch (auf Pathogenität) oder Endotoxinproduzenten schliessen. Das Anzüchten von Bakterien und Pilzen auf Agar, dauert einige Tage, bis eine gesicherte Aussage gemacht werden kann

Endotoxin Test
Es gibt auch die Möglichkeit, zu bestimmen, ob deine Probe einen gewissen Wert an Endotoxin Belastung überschreitet oder nicht. Hierzu wird mit dem bewährten LAL Test gearbeitet. Nach kürzester Zeit, kann ich dir bereits die Ergebnisse dieses Endotoxintests mitteilen.
